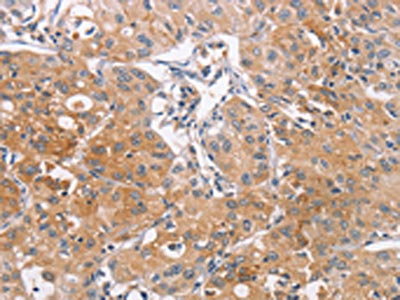

CDCA4 Antibody
-
中文名稱:CDCA4兔多克隆抗體
-
貨號:CSB-PA198566
-
規格:¥1100
-
圖片:
-
The image on the left is immunohistochemistry of paraffin-embedded Human thyroid cancer tissue using CSB-PA198566(CDCA4 Antibody) at dilution 1/50, on the right is treated with synthetic peptide. (Original magnification: ×200)
-
The image on the left is immunohistochemistry of paraffin-embedded Human lung cancer tissue using CSB-PA198566(CDCA4 Antibody) at dilution 1/50, on the right is treated with synthetic peptide. (Original magnification: ×200)
-
-
其他:
產品詳情
-
Uniprot No.:
-
基因名:CDCA4
-
別名:CDCA 4 antibody; Cdca4 antibody; CDCA4_HUMAN antibody; Cell division cycle associated 4 antibody; Cell division cycle-associated protein 4 antibody; FLJ20764 antibody; FLJ52878 antibody; Hematopoietic progenitor protein antibody; Hepp antibody; MGC19517 antibody; SEI 3 antibody; SEI-3/HEPP antibody; SEI3 antibody
-
宿主:Rabbit
-
反應種屬:Human,Mouse
-
免疫原:Synthetic peptide of Human CDCA4
-
免疫原種屬:Homo sapiens (Human)
-
標記方式:Non-conjugated
-
抗體亞型:IgG
-
純化方式:Antigen affinity purification
-
濃度:It differs from different batches. Please contact us to confirm it.
-
保存緩沖液:-20°C, pH7.4 PBS, 0.05% NaN3, 40% Glycerol
-
產品提供形式:Liquid
-
應用范圍:ELISA,IHC
-
推薦稀釋比:
Application Recommended Dilution ELISA 1:1000-1:5000 IHC 1:50-1:200 -
Protocols:
-
儲存條件:Upon receipt, store at -20°C or -80°C. Avoid repeated freeze.
-
貨期:Basically, we can dispatch the products out in 1-3 working days after receiving your orders. Delivery time maybe differs from different purchasing way or location, please kindly consult your local distributors for specific delivery time.
-
用途:For Research Use Only. Not for use in diagnostic or therapeutic procedures.
相關產品
靶點詳情
-
功能:May participate in the regulation of cell proliferation through the E2F/RB pathway. May be involved in molecular regulation of hematopoietic stem cells and progenitor cell lineage commitment and differentiation.
-
基因功能參考文獻:
- The results confirmed that CDCA4 RNA interference reduced the percentage of human breast cancer cells to <50%. In addition, RNA interference of CDCA4 resulted in a significant increase in the apoptotic rate of cells. PMID: 29257222
- High CDCA4 expression is associated with malignant melanoma. PMID: 27492455
- CDCA4 participates in the regulation of cell proliferation, mainly through the E2F/retinoblastoma protein pathway PMID: 16984923
- Data suggest that CDCA4 is involved in spindle organization from prometaphase, and when anaphase begins, it may play a different role as a midzone factor involved in chromosome segregation or cytokinesis. PMID: 18498124
- an important role of CDCA4 in the context of transcriptional regulation and cell fate determination through the JUN oncogene PMID: 18572021
- Isolation of the mouse ortholog and comparison to the human protein. PMID: 11482882
顯示更多
收起更多
-
亞細胞定位:Nucleus.
-
組織特異性:Highest levels of expression in the pancreas, thymus, testis, spleen, liver, placenta and leukocytes. Relatively low levels in the lung, kidney, prostate, ovary, small intestine and colon. Hardly detectable, if at all, in the brain, skeletal muscle and he
-
數據庫鏈接:
Most popular with customers
-
YWHAB Recombinant Monoclonal Antibody
Applications: ELISA, WB, IHC, IF, FC
Species Reactivity: Human, Mouse, Rat
-
Phospho-YAP1 (S127) Recombinant Monoclonal Antibody
Applications: ELISA, WB, IHC
Species Reactivity: Human
-
-
-
-
-
-